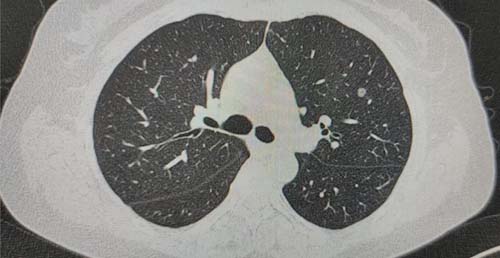
微信图片_20210528085848.jpg 微信图片_20210528085848.jpg

医院动态
【省医专家谈健康】山东第一医科大学附属省立医院胸外科张林教授:精准定位 肺小结节联合肺亚段切除术为患者提供个性化治疗
近日,山东第一医科大学附属省立医院(山东省立医院)胸外科张林教授团队完成一例左肺上叶尖后段外亚段+前段外亚段联合切除术。通过联合切除不同的肺亚段解决了段间结节或者肺组织深部结节的切除问题,为患者提供了精准的个性化治疗方案。
随着早期肺癌筛查的普及和人们健康意识的提高,肺小结节(CT上直径小于或等于3cm的肺部结节)的发现率越来越高。多年来,临床医师在肺脏病变的定位、同一肺叶内不同肺段交界平面的确定和肺段分离等技术上连续取得突破。相较于传统的肺楔形切除术和肺叶切除术,肺段切除术因其在不影响远期预后的前提下能够保护患者呼吸功能等优点而被广泛应用。但对于生长于不同肺段或位置较深,单一肺段切除难以满足肿瘤切缘要求的小结节,在切除病灶的同时,如何最大限度保护患者的呼吸功能,对临床医师的手术能力和水平提出了新要求。
张林教授对此问题进行了大量的临床探索和实践。张林教授认为,肺小结节联合亚段切除术可为患者提供更有效的个体化解决方案,即根据不同小结节的具体位置,在肺段解剖的基础上,进一步将肺段细分为不同的肺亚段单元,并以小结节为中心,个体化的精准勾画手术的切除单元,通过联合切除不同的肺亚段来解决段间结节或者肺组织深部结节的切除问题。同时,为了解决切除单元细分问题,张林教授提出了联合亚段切除手术的“三个精准”和 “五化原则”即精准解剖、精准切除、精准的余肺功能保护,手术操作的精细化,解剖结构的骨骼化,手术视野的无血化,手术切缘的无瘤化,手术切除单元的精准化。

术前CT及三维重建图像与术中切除平面的展示
在该例手术中,根据患者的CT结果,张林教授发现对小结节进行准确的术前定位较困难,而通过三维重建图像可以观察到,患者的肺小结节位于左肺的尖后段和前段之间,单纯的前段切除术难以满足安全的肿瘤切缘距离需要,而肺叶切除术又会给患者带来较大的手术创伤。张林教授团队以小结节为中心,联合切除了患者的左肺上叶尖后段外亚段+前段外亚段,在满足肿瘤切除范围的同时保护了患者的呼吸功能,减小了手术对患者带来的创伤。目前患者术后已顺利出院,术后病理结果为原位腺癌。
张林教授表示,每例手术都要根据患者结节位置制定个性化治疗方案,只有将慎于术前的小结节定位、以小结节为中心的切除单元的规划、精于术中的工匠精神的精雕细琢的精准解剖、勤于术后的快速康复的围术期管理有机结合,才能将每例手术打造为精品,让患者在获得好的预后结果的同时,术后呼吸更通畅生活质量更好。目前团队已常规开展不同部位肺小结节的联合肺亚段切除术,为肺小结节患者提供个体化的治疗。

张林,医学博士,肿瘤学博士后,主任医师,山东大学教授,省立医院大外科副主任、胸外科副主任,省立医院外科教研室教学主任,山东第一医科大学手术学教研室副主任。
中国抗癌协会肿瘤营养支持学组委员、中国老年学会食管癌康复委员会常委、山东省医学会微创分会副主任委员、山东疼痛协会胸外科专业委员会副主任委员、华北区食管青年会轮值主席、山东省医学会胸外专业委员会常委、山东省医师协会胸外科专业委员会委员、山东省抗痨协会青年委员会副主任委员、山东省抗癌协会胸部肿瘤专业委员会常委、山东省医师协会腔镜胸外科专业委员会委员,中国肺癌杂志编委、国际肿瘤杂志编委。先后获评山东省立医院十佳工匠、山东省立医院十佳青年医生、山东省省直机关职工道德模范标兵、山东省职工道德模范个人标兵、山东省富民兴鲁劳动奖章,获得山东省科技进步二等奖。

